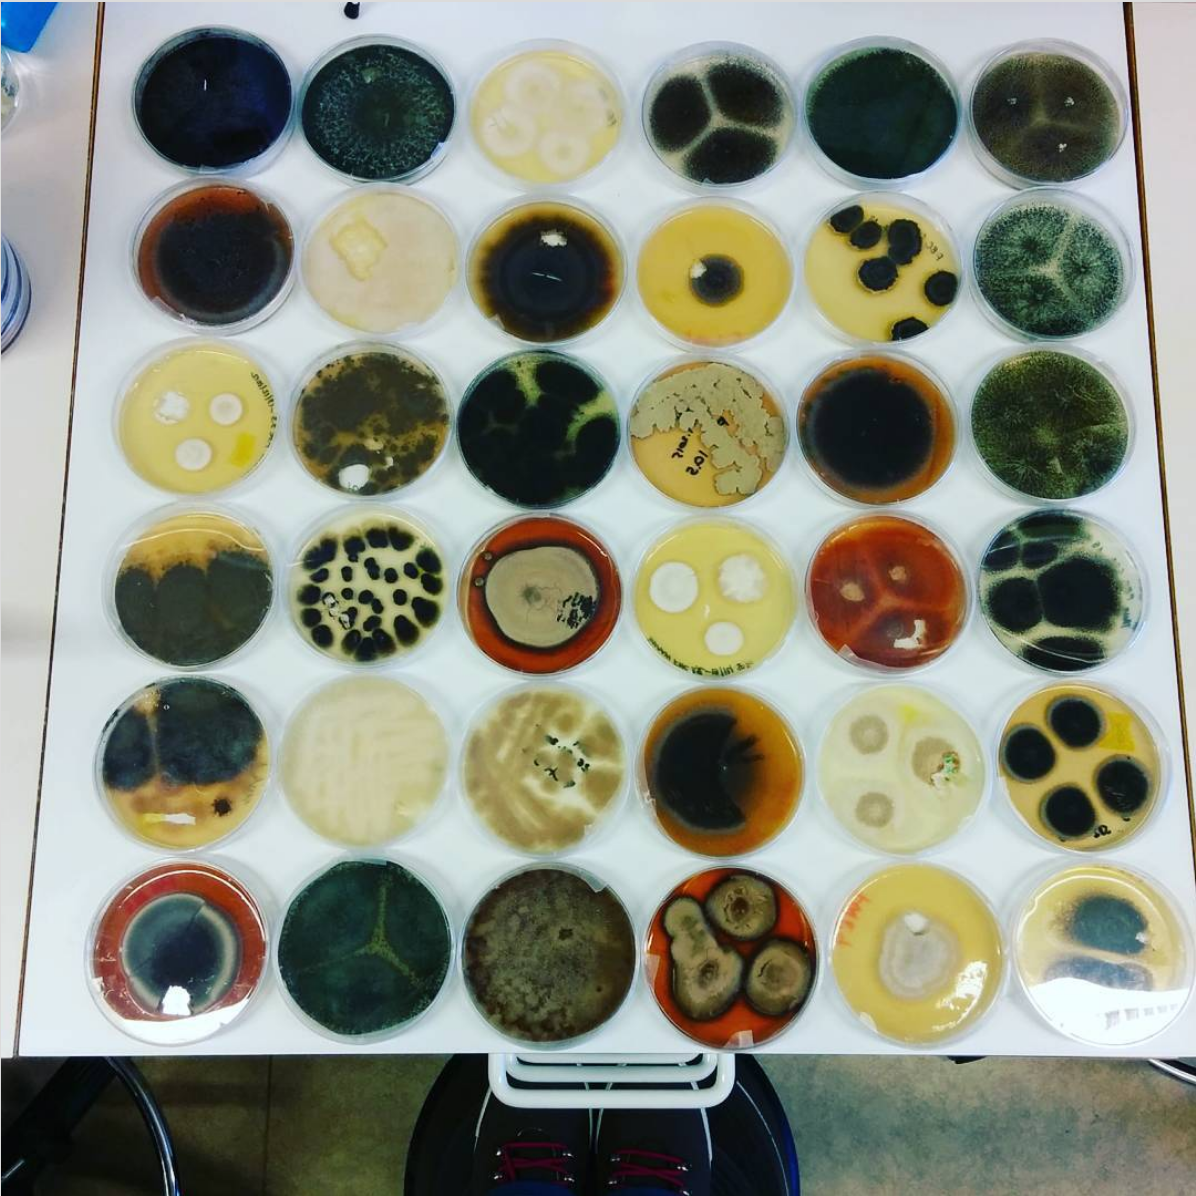

Filaments - Fungi newsletter
Whole archive can be found on Buttondown or here:
- Episode 1 - Fungi?
- Episode 2 - Eating moulds
- Episode 3 - Fungi as materials
- Episode 4 - Fungal products everywhere 1
- Episode 5 - Fungal products everywhere 2
Planned episode:
- Medical uses of fungi
- (Obscure) fungal facts and records
- Cleaning up with fungi Bioremediation with fungi
- The symbiosis with plants (mycorrhiza etc.)
- The dark side of fungi (diseases, toxins, etc.)
- Plants vs. fungi vs. pests
- Astromycology and the future of fungi
- Yeast yeast yeast
- Mycorrhizal networks
- …
Growing & finding mushrooms
- Yellow oyster mushrooms grew quite well in the living room in a perforated plastic box on top of damp Vermiculite.
- Chicken of the woods (Laetiporus, mainly L. sulphureus and L. cincinnatus) Apparently tastes more like chicken than chicken itself.
Growing filamentous fungi
Fungi collection in Industrial Biotechnology, Chalmers University of Technology, 2016. (Credit: Silvia Hüttner)
Fungi collection in Industrial Biotechnology, Chalmers University of Technology, 2016. (Credit: Silvia Hüttner)
Fungi & and notes
- Meat substitute from Aspergillus
- Filamentous fungal carriers for cultivated meat
- Combining lactic acid bacteria + fungi to utilise side and waste streams
- https://fungalpedia.org/glossary/mycoprotein/